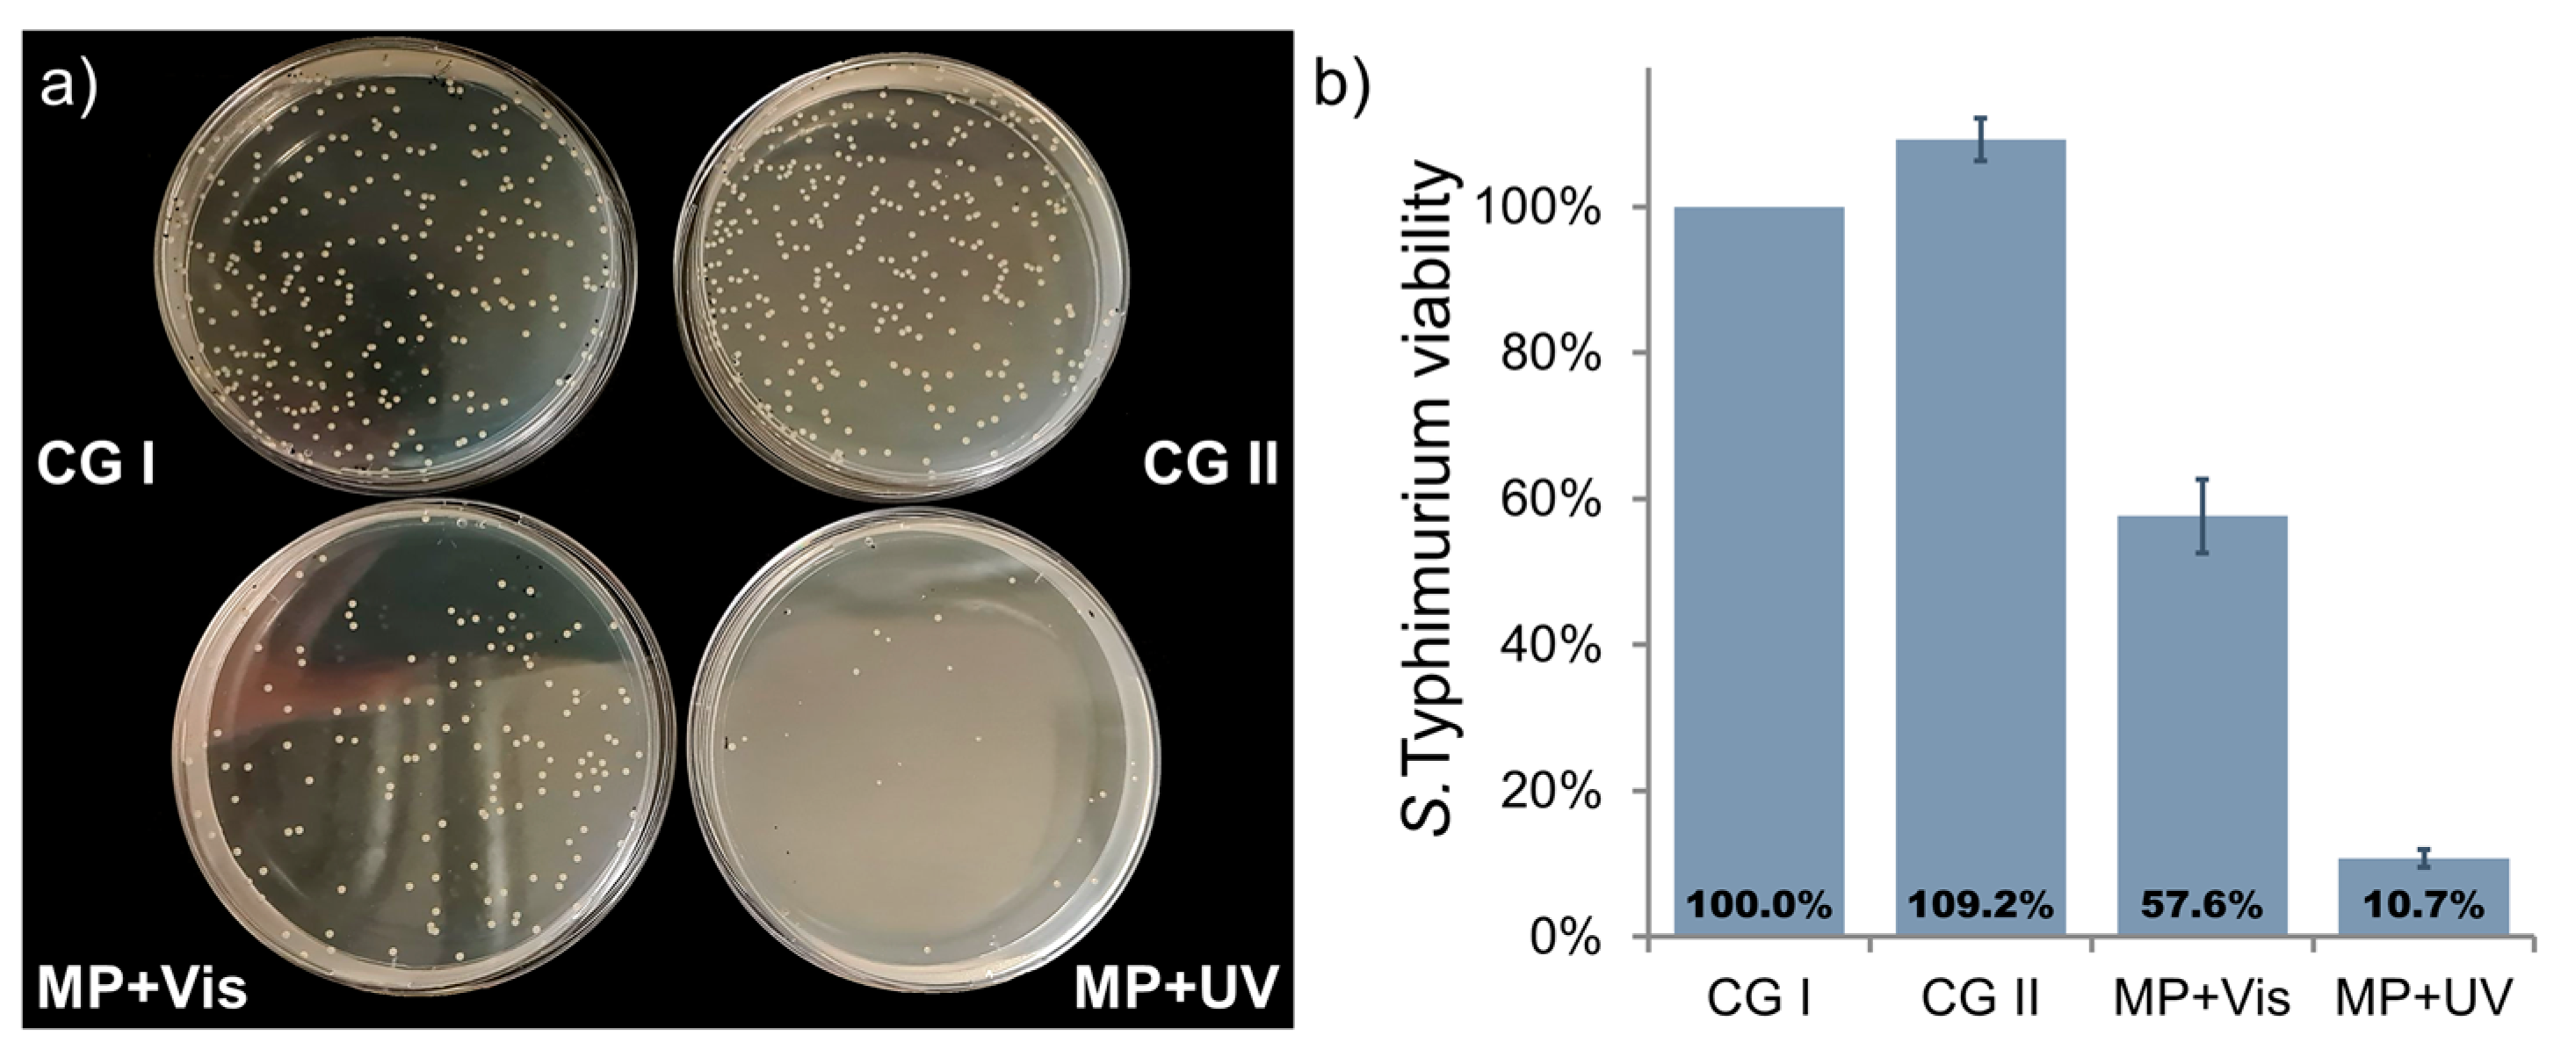
Inorganics 11 00059 g006

C-TiO2+Ni and ZnO+Ni Magnetic Photocatalyst Powder Synthesis by Reactive Magnetron Sputtering Technique and Their Application for Bacteria Inactivation
Abstract
1. Introduction
2. Results and Discussions
2.1. Characterization of C-TiO2+Ni and ZnO+Ni MP Structure
2.2. Estimation of C-TiO2+Ni and ZnO+Ni MP Photocatalytic Activity
2.2.1. Photocatalytic S. Typhimurium Bacteria Disinfection with C-TiO2+Ni MP
2.2.2. Photocatalytic S. Typhimurium Bacteria Disinfection with ZnO+Ni MP
3. Materials and Methods
3.1. Magnetic Photocatalyst Synthesis
3.2. Characterization
3.2.1. Structure Analysis
3.2.2. Repetitive Photocatalytic Bleaching of Dyes
3.2.3. Photocatalytic Bacteria Inactivation
4. Conclusions
Author Contributions
Funding
Data Availability Statement
Acknowledgments
Conflicts of Interest
References
- UNESCO World Water Assessment Programme. The United Nations World Water Development Report 2020: Water and Climate Change; UNESCO: Paris, France, 2020. [Google Scholar]
- UNESCO World Water Assessment Programme. The United Nations World Water Development Report 2021: Valuing Water; UNESCO: Paris, France, 2021. [Google Scholar]
- UNESCO World Water Assessment Programme. The United Nations World Water Development Report 2022: Groundwater: Making the Invisible Visible; UNESCO: Paris, France, 2022. [Google Scholar]
- Reznik, A.; Dinar, A.; Hernández-Sancho, F. Treated Wastewater Reuse: An Efficient and Sustainable Solution for Water Resource Scarcity. Environ. Resour. Econ. 2019, 74, 1647–1685. [Google Scholar] [CrossRef]
- Faragò, M.; Damgaard, A.; Madsen, J.A.; Andersen, J.K.; Thornberg, D.; Andersen, M.H.; Rygaard, M. From wastewater treatment to water resource recovery: Environmental and economic impacts of full-scale implementation. Water Res. 2021, 204, 117554. [Google Scholar] [CrossRef] [PubMed]
- Crosson, C.; Tong, D.; Zhang, Y.; Zhong, Q. Rainwater as a renewable resource to achieve net zero urban water in water stressed cities. Resour. Conserv. Recycl. 2021, 164, 105203. [Google Scholar] [CrossRef]
- Huang, Z.; Nya, E.L.; Rahman, M.A.; Mwamila, T.B.; Cao, V.; Gwenzi, W.; Noubactep, C. Integrated Water Resource Management: Rethinking the Contribution of Rainwater Harvesting. Sustainability 2021, 13, 8338. [Google Scholar] [CrossRef]
- Rahaman, M.F.; Jahan, C.S.; Mazumder, Q.H. Rainwater harvesting: Practiced potential for Integrated Water Resource Management in drought-prone Barind Tract, Bangladesh. Groundw. Sustain. Dev. 2019, 9, 100267. [Google Scholar] [CrossRef]
- Ding, X.; Cai, Z.; Fu, Z. Does the new-type urbanization construction improve the efficiency of agricultural green water utilization in the Yangtze River Economic Belt? Environ. Sci. Pollut. Res. 2021, 28, 64103–64112. [Google Scholar] [CrossRef]
- Paumo, H.K.; Dalhatou, S.; Katata-Seru, L.M.; Kamdem, B.P.; Tijani, J.O.; Vishwanathan, V.; Kane, A.; Bahadur, I. TiO2 assisted photocatalysts for degradation of emerging organic pollutants in water and wastewater. J. Mol. Liq. 2021, 331, 115458. [Google Scholar] [CrossRef]
- Zhang, C.; Xu, L.; Mou, X.; Xu, H.; Liu, J.; Miao, Y.; Wang, X.C.; Li, X. Characterization and evolution of antibiotic resistance of Salmonella in municipal wastewater treatment plants. J. Environ. Manag. 2019, 251, 109547. [Google Scholar] [CrossRef]
- Al-Abri, M.; Al-Ghafri, B.; Bora, T.; Dobretsov, S.; Dutta, J.; Castelletto, S.; Rosa, L.; Boretti, A. Chlorination disadvantages and alternative routes for biofouling control in reverse osmosis desalination. npj Clean Water 2019, 2, 2. [Google Scholar] [CrossRef]
- Pedahzur, R.; Katzenelson, D.; Barnea, N.; Lev, O.; Shuval, H.I.; Fattal, B.; Ulitzur, S. The efficacy of long-lasting residual drinking water disinfectants based on hydrogen peroxide and silver. Water Sci. Technol. 2000, 42, 293–298. [Google Scholar] [CrossRef]
- Letifi, H.; Dridi, D.; Litaiem, Y.; Ammar, S.; Dimassi, W.; Chtourou, R. High Efficient and Cost Effective Titanium Doped Tin Dioxide Based Photocatalysts Synthesized via Co-precipitation Approach. Catalysts 2021, 11, 803. [Google Scholar] [CrossRef]
- Ray, S.K.; Dhakal, D.; Regmi, C.; Yamaguchui, T.; Lee, S.W. Inactivation of Staphylococcus aureus in visible light by morphology tuned α-NiMoO4. J. Photochem. Photobiol. A Chem. 2018, 350, 59–68. [Google Scholar] [CrossRef]
- García-Espinoza, J.D.; Robles, I.; Durán-Moreno, A.; Godínez, L.A. Photo-assisted electrochemical advanced oxidation processes for the disinfection of aqueous solutions: A review. Chemosphere 2021, 274, 129957. [Google Scholar] [CrossRef] [PubMed]
- Du, Y.; Xiong, H.; Dong, S.; Zhang, J.; Ma, D.; Zhou, D. Identifying the role of reactive oxygen species (ROSs) in Fusarium solani spores inactivation. AMB Express 2016, 6, 81. [Google Scholar] [CrossRef]
- Hasija, V.; Kumar, A.; Sudhaik, A.; Raizada, P.; Singh, P.; Van Le, Q.; Le, T.T.; Nguyen, V.-H. Step-scheme heterojunction photocatalysts for solar energy, water splitting, CO2 conversion, and bacterial inactivation: A review. Environ. Chem. Lett. 2021, 19, 2941–2966. [Google Scholar] [CrossRef]
- Bhatkhande, D.S.; Pangarkar, V.G.; Beenackers, A.A.C.M. Photocatalytic degradation for environmental applications—A review. J. Chem. Technol. Biotechnol. 2002, 77, 102–116. [Google Scholar] [CrossRef]
- Thongam, D.D.; Chaturvedi, H. Advances in nanomaterials for heterogeneous photocatalysis. Nano Express 2021, 2, 12005. [Google Scholar] [CrossRef]
- Piątkowska, A.; Janus, M.; Szymański, K.; Mozia, S. C-,N- and S-Doped TiO2 Photocatalysts: A Review. Catalysts 2021, 11, 144. [Google Scholar] [CrossRef]
- Lee, K.M.; Lai, C.W.; Ngai, K.S.; Juan, J.C. Recent developments of zinc oxide based photocatalyst in water treatment technology: A review. Water Res. 2016, 88, 428–448. [Google Scholar] [CrossRef]
- Lofrano, G.; Ubaldi, F.; Albarano, L.; Carotenuto, M.; Vaiano, V.; Valeriani, F.; Libralato, G.; Gianfranceschi, G.; Fratoddi, I.; Meric, S.; et al. Antimicrobial Effectiveness of Innovative Photocatalysts: A Review. Nanomaterials 2022, 12, 2831. [Google Scholar] [CrossRef]
- Gogoi, D.; Namdeo, A.; Golder, A.K.; Peela, N.R. Ag-doped TiO2 photocatalysts with effective charge transfer for highly efficient hydrogen production through water splitting. Int. J. Hydrogen Energy 2020, 45, 2729–2744. [Google Scholar] [CrossRef]
- Mollavali, M.; Rohani, S.; Elahifard, M.; Behjatmanesh-Ardakani, R.; Nourany, M. Band gap reduction of (Mo+N) co-doped TiO2 nanotube arrays with a significant enhancement in visible light photo-conversion: A combination of experimental and theoretical study. Int. J. Hydrogen Energy 2021, 46, 21475–21498. [Google Scholar] [CrossRef]
- Bakar, S.A.; Ribeiro, C. Nitrogen-doped titanium dioxide: An overview of material design and dimensionality effect over modern applications. J. Photochem. Photobiol. C Photochem. Rev. 2016, 27, 1–29. [Google Scholar] [CrossRef]
- Changanaqui, K.; Brillas, E.; Alarcón, H.; Sirés, I. ZnO/TiO2/Ag2Se nanostructures as photoelectrocatalysts for the degradation of oxytetracycline in water. Electrochim. Acta 2020, 331, 135194. [Google Scholar] [CrossRef]
- Hunger, M.; Hüsken, G.; Brouwers, H.J.H. Photocatalytic degradation of air pollutants—From modeling to large scale application. Cem. Concr. Res. 2010, 40, 313–320. [Google Scholar] [CrossRef]
- Tang, T.; Yin, Z.; Chen, J.; Zhang, S.; Sheng, W.; Wei, W.; Xiao, Y.; Shi, Q.; Cao, S. Novel p-n heterojunction Bi2O3/Ti3+-TiO2 photocatalyst enables the complete removal of tetracyclines under visible light. Chem. Eng. J. 2021, 417, 128058. [Google Scholar] [CrossRef]
- Yu, J.; Low, J.; Xiao, W.; Zhou, P.; Jaroniec, M. Enhanced Photocatalytic CO2-Reduction Activity of Anatase TiO2 by Coexposed {001} and {101} Facets. J. Am. Chem. Soc. 2014, 136, 8839–8842. [Google Scholar] [CrossRef]
- Ong, W.-J.; Tan, L.-L.; Chai, S.-P.; Yong, S.-T.; Mohamed, A.R. Highly reactive {001} facets of TiO2-based composites: Synthesis, formation mechanism and characterization. Nanoscale 2014, 6, 1946–2008. [Google Scholar] [CrossRef]
- Xu, Q.; Zhang, L.; Yu, J.; Wageh, S.; Al-Ghamdi, A.A.; Jaroniec, M. Direct Z-scheme photocatalysts: Principles, synthesis, and applications. Mater. Today 2018, 21, 1042–1063. [Google Scholar] [CrossRef]
- Wang, J.; Wang, G.; Cheng, B.; Yu, J.; Fan, J. Sulfur-doped g-C3N4/TiO2 S-scheme heterojunction photocatalyst for Congo Red photodegradation. Chin. J. Catal. 2021, 42, 56–68. [Google Scholar] [CrossRef]
- Fu, J.; Xu, Q.; Low, J.; Jiang, C.; Yu, J. Ultrathin 2D/2D WO3/g-C3N4 step-scheme H2-production photocatalyst. Appl. Catal. B Environ. 2019, 243, 556–565. [Google Scholar] [CrossRef]
- Feng, X.; Yu, Z.; Sun, Y.; Shan, M.; Long, R.; Li, X. 3D MXene/Ag2S material as Schottky junction catalyst with stable and enhanced photocatalytic activity and photocorrosion resistance. Sep. Purif. Technol. 2021, 266, 118606. [Google Scholar] [CrossRef]
- Li, W.; Chu, X.; He, S.; Wang, X.; Wang, C. A gourd-like hollow mesoporous silica particle-supported Ag/AgBr Schottky junction for highly efficient mineralization of tetracycline hydrochloride. Environ. Sci. Nano 2020, 7, 2654–2668. [Google Scholar] [CrossRef]
- Ivanova, I.; Schneider, J.; Gutzmann, H.; Kliemann, J.O.; Gärtner, F.; Klassen, T.; Bahnemann, D.; Mendive, C.B. Photocatalytic degradation of oxalic and dichloroacetic acid on TiO 2 coated metal substrates. Catal. Today 2013, 209, 84–90. [Google Scholar] [CrossRef]
- Wenhua, L.; Hong, L.; Sao’an, C.; Jianqing, Z.; Chunan, C. Kinetics of photocatalytic degradation of aniline in water over TiO2 supported on porous nickel. J. Photochem. Photobiol. A Chem. 2000, 131, 125–132. [Google Scholar] [CrossRef]
- Liu, Y.; Zhu, X.; Yuan, D.; Wang, W.; Gao, L. Preparation and characterization of TiO2 based on wood templates. Sci. Rep. 2020, 10, 12444. [Google Scholar] [CrossRef]
- Hu, X.; Hu, X.; Tang, C.; Wen, S.; Wu, X.; Long, J.; Yang, X.; Wang, H.; Zhou, L. Mechanisms underlying degradation pathways of microcystin-LR with doped TiO2 photocatalysis. Chem. Eng. J. 2017, 330, 355–371. [Google Scholar] [CrossRef]
- Li, Y.-F.; Liu, Z.-P. Particle Size, Shape and Activity for Photocatalysis on Titania Anatase Nanoparticles in Aqueous Surroundings. J. Am. Chem. Soc. 2011, 133, 15743–15752. [Google Scholar] [CrossRef]
- Mirzaeifard, Z.; Shariatinia, Z.; Jourshabani, M.; Rezaei Darvishi, S.M. ZnO Photocatalyst Revisited: Effective Photocatalytic Degradation of Emerging Contaminants Using S-Doped ZnO Nanoparticles under Visible Light Radiation. Ind. Eng. Chem. Res. 2020, 59, 15894–15911. [Google Scholar] [CrossRef]
- Xiu, Z.; Guo, M.; Zhao, T.; Pan, K.; Xing, Z.; Li, Z.; Zhou, W. Recent advances in Ti3+ self-doped nanostructured TiO2 visible light photocatalysts for environmental and energy applications. Chem. Eng. J. 2020, 382, 123011. [Google Scholar] [CrossRef]
- Ruiz-Aguirre, A.; Villachica-Llamosas, J.G.; Polo-López, M.I.; Cabrera-Reina, A.; Colón, G.; Peral, J.; Malato, S. Assessment of pilot-plant scale solar photocatalytic hydrogen generation with multiple approaches: Valorization, water decontamination and disinfection. Energy 2022, 260, 125199. [Google Scholar] [CrossRef]
- Veréb, G.; Hernádi, K.; Baia, L.; Rákhely, G.; Pap, Z. Chapter 12—Pilot-plant scaled water treatment technologies, standards for the removal of contaminants of emerging concern based on photocatalytic materials. In Micro and Nano Technologies; Baia, L., Pap, Z., Hernadi, K., Baia, M., Eds.; Elsevier: Amsterdam, The Netherlands, 2020; pp. 493–523. [Google Scholar]
- Shan, A.Y.; Ghazi, T.I.M.; Rashid, S.A. Immobilisation of titanium dioxide onto supporting materials in heterogeneous photocatalysis: A review. Appl. Catal. A Gen. 2010, 389, 1–8. [Google Scholar] [CrossRef]
- Srikanth, B.; Goutham, R.; Badri Narayan, R.; Ramprasath, A.; Gopinath, K.P.; Sankaranarayanan, A.R. Recent advancements in supporting materials for immobilised photocatalytic applications in waste water treatment. J. Environ. Manag. 2017, 200, 60–78. [Google Scholar] [CrossRef] [PubMed]
- Beydoun, D.; Amal, R.; Low, G.K.-C.; McEvoy, S. Novel Photocatalyst: Titania-Coated Magnetite. Activity and Photodissolution. J. Phys. Chem. B 2000, 104, 4387–4396. [Google Scholar] [CrossRef]
- Beydoun, D.; Amal, R. Implications of heat treatment on the properties of a magnetic iron oxide–titanium dioxide photocatalyst. Mater. Sci. Eng. B 2002, 94, 71–81. [Google Scholar] [CrossRef]
- Jacinto, M.J.; Ferreira, L.F.; Silva, V.C. Magnetic materials for photocatalytic applications—A review. J. Sol-Gel Sci. Technol. 2020, 96, 1–14. [Google Scholar] [CrossRef]
- Elgohary, E.A.; Mohamed, Y.M.A.; El Nazer, H.A.; Baaloudj, O.; Alyami, M.S.S.; El Jery, A.; Assadi, A.A.; Amrane, A. A Review of the Use of Semiconductors as Catalysts in the Photocatalytic Inactivation of Microorganisms. Catalysts 2021, 11, 1498. [Google Scholar] [CrossRef]
- Varnagiris, S.; Urbonavičius, M.; Sakalauskaitė, S.; Demikyte, E.; Tuckute, S. Floating Carbon-Doped TiO2 Photocatalyst with Metallic Underlayers Investigation for Polluted Water Treatment under Visible-Light Irradiation. Catalysts 2021, 11, 1454. [Google Scholar] [CrossRef]
- Sakalauskaite, S.; Vasiliauske, D.; Demikyte, E.; Daugelavicius, R.; Lelis, M. Influence of the Metabolic Activity of Microorganisms on Disinfection Efficiency of the Visible Light and P25 TiO2 Photocatalyst. Catalysts 2021, 11, 1432. [Google Scholar] [CrossRef]
- Restifo, L.L.; Vogelbacker, H.H.; Madara, T.; Ling, S.K.; Kozinski, A.W. Effects of UV irradiation on the fate of 5-bromodeoxyuridine-substituted bacteriophage T4 DNA. J. Virol. 1983, 47, 151–170. [Google Scholar] [CrossRef]
- Ellmer, K. Magnetron sputtering of transparent conductive zinc oxide: Relation between the sputtering parameters and the electronic properties. J. Phys. D Appl. Phys. 2000, 33, R17–R32. [Google Scholar] [CrossRef]
- Tučkutė, S.; Urbonavičius, M.; Lelis, M.; Maiorov, M.; Ordaz, J.R.D.; Milčius, D. A new method of nanocrystalline nickel powder formation by magnetron sputtering on the water-soluble substrates. Mater. Res. Express 2018, 5, 015017. [Google Scholar] [CrossRef]
- Varnagiris, S.; Medvids, A.; Lelis, M.; Milcius, D.; Antuzevics, A. Black carbon-doped TiO2 films: Synthesis, characterization and photocatalysis. J. Photochem. Photobiol. A Chem. 2019, 382, 111941. [Google Scholar] [CrossRef]
- Lelis, M.; Varnagiris, S.; Urbonavicius, M.; Zakarauskas, K. Investigation of Catalyst Development from Mg2NiH4 Hydride and Its Application for the CO2 Methanation Reaction. Coatings 2020, 10, 1178. [Google Scholar] [CrossRef]
- Bockute, K.; Demikyte, E.; Tuckute, S.; Urbonavičius, M.; Varnagiris, S.; Laukaitis, G.; Lelis, M. Photoluminescence and structural defects of ZnO films deposited by reactive magnetron sputtering with unconventional Ar-O2 gas mixture formation. In Proceedings of the SurfCoat Korea 2021, Online, 26–28 May 2021; pp. 2–8. [Google Scholar]
- Wu, H.; Ma, J.; Zhang, C.; He, H. Effect of TiO2 calcination temperature on the photocatalytic oxidation of gaseous NH3. J. Environ. Sci. 2014, 26, 673–682. [Google Scholar] [CrossRef] [PubMed]
- Sienkiewicz, A.; Wanag, A.; Kusiak-Nejman, E.; Ekiert, E.; Rokicka-Konieczna, P.; Morawski, A.W. Effect of calcination on the photocatalytic activity and stability of TiO2 photocatalysts modified with APTES. J. Environ. Chem. Eng. 2021, 9, 104794. [Google Scholar] [CrossRef]
- Andia-Huaracha, S.C.; Zapana-Cayo, L.M.; Aragón, F.F.H.; Aquino, J.C.R.; Coaquira, J.A.H.; Gonzales-Lorenzo, C.D.; Ayala-Arenas, J.S.; Solis, J.L.; Morais, P.C.; Pacheco-Salazar, D.G. Tuning the photocatalytic activity of ZnO nanoparticles by the annihilation of intrinsic defects provoked by the thermal annealing. J. Nanopart. Res. 2022, 24, 50. [Google Scholar] [CrossRef]
- Springthorpe, A.J. The Rhombohedral Distortion in NiO. In Physica Status Solidi; Gutsche, E., Müller, K., Görlich, P., Eds.; De Gruyter: Berlin, Germany; Boston, MA, USA, 1967; pp. 399–400. [Google Scholar]
- He, G.; Zhang, H.; Ni, J.; Liu, B.; Xu, C.; Xiang, H. Microscopic Magnetic Origin of Rhombohedral Distortion in NiO. Chin. Phys. Lett. 2022, 39, 67501. [Google Scholar] [CrossRef]
- Hotovy, I.; Huran, J.; Spiess, L. Characterization of sputtered NiO films using XRD and AFM. J. Mater. Sci. 2004, 39, 2609–2612. [Google Scholar] [CrossRef]
- Zhang, L.; Tse, M.S.; Tan, O.K.; Wang, Y.X.; Han, M. Facile fabrication and characterization of multi-type carbon-doped TiO2 for visible light-activated photocatalytic mineralization of gaseous toluene. J. Mater. Chem. A 2013, 1, 4497–4507. [Google Scholar] [CrossRef]
- Ząbek, P.; Eberl, J.; Kisch, H. On the origin of visible light activity in carbon-modified titania. Photochem. Photobiol. Sci. 2009, 8, 264–269. [Google Scholar] [CrossRef] [PubMed]
- Chen, X.; Wang, X.; Fang, D. A review on C1s XPS-spectra for some kinds of carbon materials. Fuller. Nanotub. Carbon Nanostruct. 2020, 28, 1048–1058. [Google Scholar] [CrossRef]
- Byrne, C.; Subramanian, G.; Pillai, S.C. Recent advances in photocatalysis for environmental applications. J. Environ. Chem. Eng. 2018, 6, 3531–3555. [Google Scholar] [CrossRef]
- Ohno, T.; Tokieda, K.; Higashida, S.; Matsumura, M. Synergism between rutile and anatase TiO2 particles in photocatalytic oxidation of naphthalene. Appl. Catal. A Gen. 2003, 244, 383–391. [Google Scholar] [CrossRef]
- Liu, H.; Yang, W.; Ma, Y.; Yao, J. Extended visible light response of binary TiO2-Ti 2O3 photocatalyst prepared by a photo-assisted sol-gel method. Appl. Catal. A Gen. 2006, 299, 218–223. [Google Scholar] [CrossRef]
- Grabstanowicz, L.R.; Gao, S.; Li, T.; Rickard, R.M.; Rajh, T.; Liu, D.J.; Xu, T. Facile oxidative conversion of TiH2 to high-concentration Ti3+-self-doped rutile TiO2 with visible-light photoactivity. Inorg. Chem. 2013, 52, 3884–3890. [Google Scholar] [CrossRef]
- Atla, S.B.; Chen, C.-C.; Chen, C.-Y.; Lin, P.-Y.; Pan, W.; Cheng, K.-C.; Huang, Y.M.; Chang, Y.-F.; Jean, J.-S. Visible light response of Ag+/TiO2–Ti2O3 prepared by photodeposition under foam fractionation. J. Photochem. Photobiol. A Chem. 2012, 236, 1–8. [Google Scholar] [CrossRef]
- Yang, Y.; Ni, D.; Yao, Y.; Zhong, Y.; Ma, Y.; Yao, J. High photocatalytic activity of carbon doped TiO2 prepared by fast combustion of organic capping ligands. RSC Adv. 2015, 5, 93635–93643. [Google Scholar] [CrossRef]
- Shao, J.; Sheng, W.; Wang, M.; Li, S.; Chen, J.; Zhang, Y.; Cao, S. In situ synthesis of carbon-doped TiO2 single-crystal nanorods with a remarkably photocatalytic efficiency. Appl. Catal. B Environ. 2017, 209, 311–319. [Google Scholar] [CrossRef]
- Kunj, S.; Sreenivas, K. Residual stress and defect content in magnetron sputtered ZnO films grown on unheated glass substrates. Curr. Appl. Phys. 2016, 16, 748–756. [Google Scholar] [CrossRef]
- Suo, X.; Zhao, S.; Ran, Y.; Liu, H.; Jiang, Z.; Li, Y.; Wang, Z. Effects of oxygen/argon pressure ratio on the structural and optical properties of Mn-doped ZnO thin films prepared by magnetron pulsed co-sputtering. Surf. Coat. Technol. 2019, 357, 978–983. [Google Scholar] [CrossRef]
- Cicek, K.; Karacali, T.; Efeoglu, H.; Cakmak, B. Deposition of ZnO thin films by RF&DC magnetron sputtering on silicon and porous-silicon substrates for pyroelectric applications. Sens. Actuators A Phys. 2017, 260, 24–28. [Google Scholar]
- Younas, R.; Afzal, N.; Rafique, M.; Imran, M.; Saleem, M.; Ahmad, R. Nickel ion implantation effects on DC magnetron sputtered ZnO film prepared on Si (100). Ceram. Int. 2019, 45, 15547–15555. [Google Scholar] [CrossRef]
- Ievtushenko, A.I.; Karpyna, V.A.; Lazorenko, V.I.; Lashkarev, G.V.; Khranovskyy, V.D.; Baturin, V.A.; Karpenko, O.Y.; Lunika, M.M.; Avramenko, K.A.; Strelchuk, V.V.; et al. High quality ZnO films deposited by radio-frequency magnetron sputtering using layer by layer growth method. Thin Solid Films 2010, 518, 4529–4532. [Google Scholar] [CrossRef]
- Wang, Y.; Chu, B. Structural and optical properties of ZnO thin films on (111) CaF2 substrates grown by magnetron sputtering. Superlattices Microstruct. 2008, 44, 54–61. [Google Scholar] [CrossRef]
- Yau, W.-H.; Tseng, P.-C.; Lian, D. Nanoscratch study of ZnO thin films deposited using radio frequency magnetron sputtering. Nucl. Instrum. Methods Phys. Res. Sect. B Beam Interact. Mater. Atoms 2011, 269, 1450–1454. [Google Scholar] [CrossRef]
- Vempati, S.; Mitra, J.; Dawson, P. One-step synthesis of ZnO nanosheets: A blue-white fluorophore. Nanoscale Res. Lett. 2012, 7, 470. [Google Scholar] [CrossRef]
- Kayaci, F.; Vempati, S.; Donmez, I.; Biyikli, N.; Uyar, T. Role of zinc interstitials and oxygen vacancies of ZnO in photocatalysis: A bottom-up approach to control defect density. Nanoscale 2014, 6, 10224–10234. [Google Scholar] [CrossRef]
- Urbonavicius, M.; Varnagiris, S.; Tuckute, S.; Sakalauskaite, S.; Demikyte, E.; Lelis, M. Visible-Light-Driven Photocatalytic Inactivation of Bacteria, Bacteriophages, and Their Mixtures Using ZnO-Coated HDPE Beads as Floating Photocatalyst. Materials 2022, 15, 1318. [Google Scholar] [CrossRef]
- Mikami, M.; Eto, T.; Wang, J.; Masa, Y.; Isshiki, M. Growth of zinc oxide by chemical vapor transport. J. Cryst. Growth 2005, 276, 389–392. [Google Scholar] [CrossRef]
- NIST. X-ray Photoelectron Spectroscopy Database, Version 4.1; NIST Standard Reference Database 20; NIST: Gaithersburg, MD, USA, 2012.
- Abdel-Wahab, M.S.; Jilani, A.; Yahia, I.S.; Al-Ghamdi, A.A. Enhanced the photocatalytic activity of Ni-doped ZnO thin films: Morphological, optical and XPS analysis. Superlattices Microstruct. 2016, 94, 108–118. [Google Scholar] [CrossRef]
- Guo, H.-L.; Zhu, Q.; Wu, X.-L.; Jiang, Y.-F.; Xie, X.; Xu, A.-W. Oxygen deficient ZnO1−x nanosheets with high visible light photocatalytic activity. Nanoscale 2015, 7, 7216–7223. [Google Scholar] [CrossRef] [PubMed]
- Al-Gaashani, R.; Radiman, S.; Daud, A.R.; Tabet, N.; Al-Douri, Y. XPS and optical studies of different morphologies of ZnO nanostructures prepared by microwave methods. Ceram. Int. 2013, 39, 2283–2292. [Google Scholar] [CrossRef]
- Verdier, T.; Coutand, M.; Bertron, A.; Roques, C. Antibacterial Activity of TiO2 Photocatalyst Alone or in Coatings on E. coli: The Influence of Methodological Aspects. Coatings 2014, 4, 670–686. [Google Scholar] [CrossRef]
- Kumar, P.; Mathpal, M.C.; Inwati, G.K.; Ghosh, S.; Kumar, V.; Roos, W.D.; Swart, H.C. Optical and surface properties of Zn doped CdO nanorods and antimicrobial applications. Colloids Surf. A Physicochem. Eng. Asp. 2020, 605, 125369. [Google Scholar] [CrossRef]
- Cataño, F.A.; Valencia, S.; Hincapié, E.A.; Restrepo, G.; Marín, J.M. A Comparative study between TiO2 and ZnO photocatalysis: Photocatalytic degradation of cibacron yellow FN-2R dye. Lat. Am. Appl. Res. 2012, 42, 33–38. [Google Scholar]
- Li, Y.; Xie, S.; Xu, D.; Shu, G.; Wang, X. Antibacterial activity of ZnO quantum dots and its protective effects of chicks infected with Salmonella pullorum. Nanotechnology 2021, 32, 505104. [Google Scholar] [CrossRef]
- Ye, X.J.; Zhong, W.; Xu, M.H.; Qi, X.S.; Au, C.T.; Du, Y.W. The magnetic property of carbon-doped TiO2. Phys. Lett. A 2009, 373, 3684–3687. [Google Scholar] [CrossRef]
- Ablat, A.; Wu, R.; Mamat, M.; Ghupur, Y.; Aimidula, A.; Bake, M.A.; Gholam, T.; Wang, J.; Qian, H.; Wu, R.; et al. Electronic structure and room temperature ferromagnetism of C doped TiO2. Solid State Commun. 2016, 243, 7–11. [Google Scholar] [CrossRef]
- Garcia, M.A.; Merino, J.M.; Fernández Pinel, E.; Quesada, A.; de la Venta, J.; Ruíz González, M.L.; Castro, G.R.; Crespo, P.; Llopis, J.; González-Calbet, J.M.; et al. Magnetic Properties of ZnO Nanoparticles. Nano Lett. 2007, 7, 1489–1494. [Google Scholar] [CrossRef]
- Limón-Rocha, I.; Marizcal-Barba, A.; Guzmán-González, C.A.; Anaya-Esparza, L.M.; Ghotekar, S.; González-Vargas, O.A.; Pérez-Larios, A. Co, Cu, Fe, and Ni Deposited over TiO2 and Their Photocatalytic Activity in the Degradation of 2,4-Dichlorophenol and 2,4-Dichlorophenoxyacetic Acid. Inorganics 2022, 10, 157. [Google Scholar] [CrossRef]
- Yeh, T.-S.; Wu, J.-M.; Hu, L.-J. The properties of TiN thin films deposited by pulsed direct current magnetron sputtering. Thin Solid Films 2008, 516, 7294–7298. [Google Scholar] [CrossRef]
- Cooke, K.E.; Hampshire, J.; Southall, W.; Teer, D.G. Industrial Application of Pulsed Dc Bias Power Supplies in Closed Field Unbalanced Magnetron Sputter Ion Plating. Surf. Eng. 2004, 20, 189–195. [Google Scholar] [CrossRef]
- Vlček, J.; Pajdarová, A.D.; Musil, J. Pulsed dc Magnetron Discharges and their Utilization in Plasma Surface Engineering. Contrib. Plasma Phys. 2004, 44, 426–436. [Google Scholar] [CrossRef]
- Lelis, M.; Tuckute, S.; Urbonavicius, M.; Varnagiris, S.; Demikyte, E. Non-Conventional Synthesis and Repetitive Application of Magnetic Visible Light Photocatalyst Powder Consisting of Bi-Layered C-Doped TiO2 and Ni Particles. Catalysts 2023, 13, 169. [Google Scholar] [CrossRef]

| Tetracycline, µg/mL | Chloramphenicol, µg/mL | |||
|---|---|---|---|---|
| MIC50 * | MIC90 * | MIC50 * | MIC90 * | |
| CG I | 1.2 | 2 | 3.5 | 8 |
| CG II | 0.8 | 2 | 3.5 | 8 |
| MP+Vis | 0.8 | 2 | 1.8 | 8 |
| MP+UV | 0.5 | 2 | 2.2 | 4 |
| Tetracycline, µg/mL | Chloramphenicol, µg/mL | |||
|---|---|---|---|---|
| MIC50 * | MIC90 * | MIC50 * | MIC90 * | |
| CG I | 1 | 2 | 3 | 8 |
| CG II | 0.7 | 2 | 3 | 8 |
| MP+Vis | 0.7 | 2 | 3 | 8 |
| MP+UV | 0.4 | 1 | 1 | 4 |
Disclaimer/Publisher’s Note: The statements, opinions and data contained in all publications are solely those of the individual author(s) and contributor(s) and not of MDPI and/or the editor(s). MDPI and/or the editor(s) disclaim responsibility for any injury to people or property resulting from any ideas, methods, instructions or products referred to in the content. |
© 2023 by the authors. Licensee MDPI, Basel, Switzerland. This article is an open access article distributed under the terms and conditions of the Creative Commons Attribution (CC BY) license (https://creativecommons.org/licenses/by/4.0/).
Share and Cite
Lelis, M.; Tuckute, S.; Urbonavicius, M.; Varnagiris, S.; Sakalauskaite, S.; Daugelavicius, R. C-TiO2+Ni and ZnO+Ni Magnetic Photocatalyst Powder Synthesis by Reactive Magnetron Sputtering Technique and Their Application for Bacteria Inactivation. Inorganics 2023, 11, 59. https://doi.org/10.3390/inorganics11020059
Lelis M, Tuckute S, Urbonavicius M, Varnagiris S, Sakalauskaite S, Daugelavicius R. C-TiO2+Ni and ZnO+Ni Magnetic Photocatalyst Powder Synthesis by Reactive Magnetron Sputtering Technique and Their Application for Bacteria Inactivation. Inorganics. 2023; 11(2):59. https://doi.org/10.3390/inorganics11020059
Chicago/Turabian StyleLelis, Martynas, Simona Tuckute, Marius Urbonavicius, Sarunas Varnagiris, Sandra Sakalauskaite, and Rimantas Daugelavicius. 2023. "C-TiO2+Ni and ZnO+Ni Magnetic Photocatalyst Powder Synthesis by Reactive Magnetron Sputtering Technique and Their Application for Bacteria Inactivation" Inorganics 11, no. 2: 59. https://doi.org/10.3390/inorganics11020059
APA StyleLelis, M., Tuckute, S., Urbonavicius, M., Varnagiris, S., Sakalauskaite, S., & Daugelavicius, R. (2023). C-TiO2+Ni and ZnO+Ni Magnetic Photocatalyst Powder Synthesis by Reactive Magnetron Sputtering Technique and Their Application for Bacteria Inactivation. Inorganics, 11(2), 59. https://doi.org/10.3390/inorganics11020059

